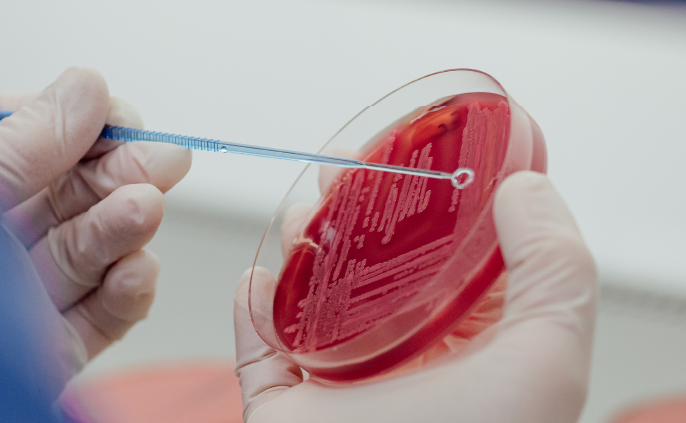
taking a sample. Ruminant disease

Inovação
para tratar & cuidar
Com os seus centros de Investigação e Desenvolvimento localizados em diferentes continentes, a Ceva está empenhada em desenvolver moléculas e combinações inovadoras para combater as doenças infecciosas dos ruminantes.











